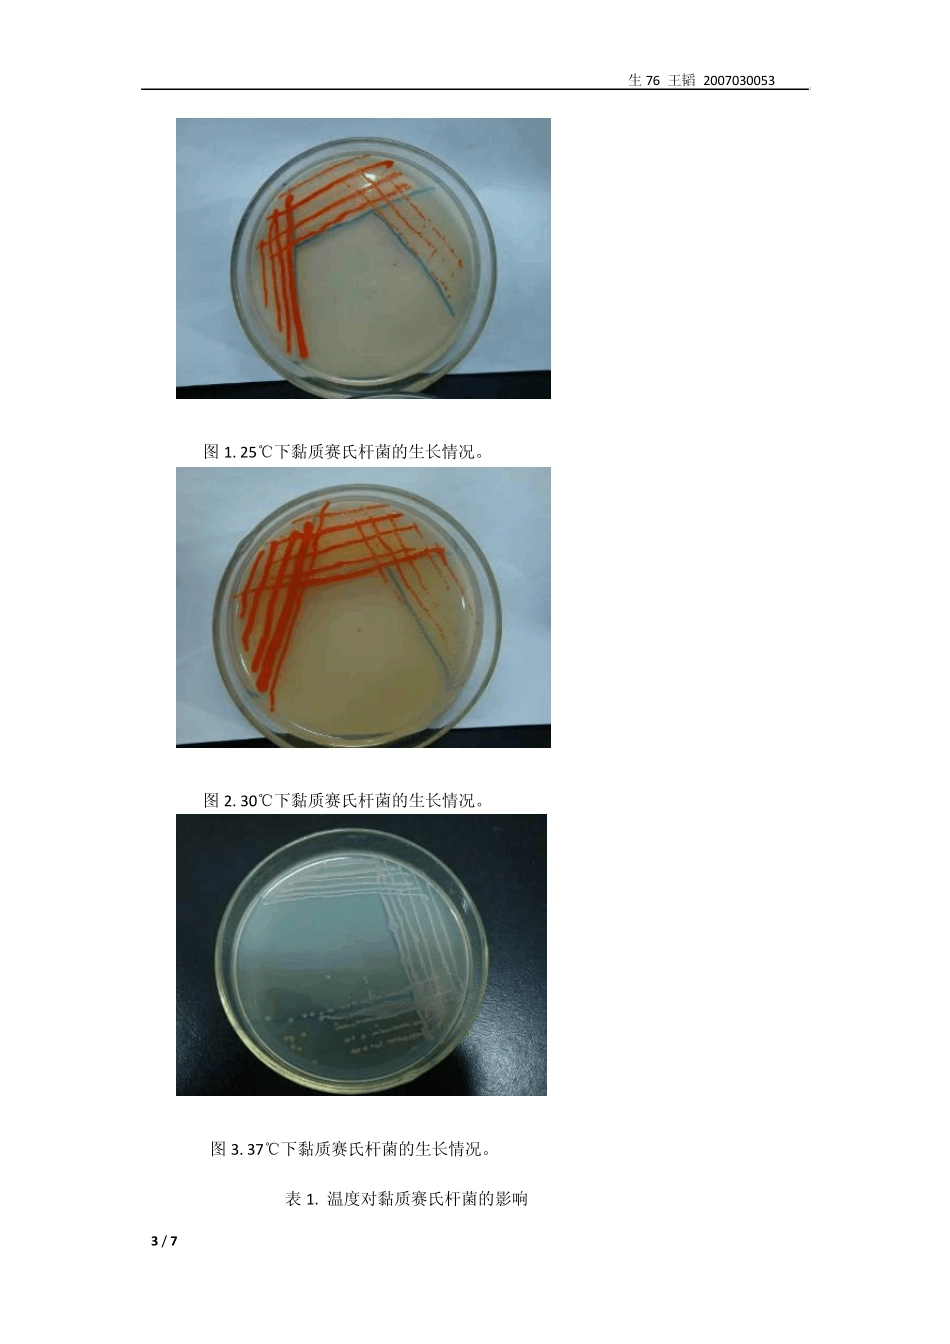
环境因素对微生物的影响和紫外诱变效应_第3页

生 76 王韬 2007030053 1 / 7 环境因素对微生物的影响和紫外诱变效应 姓名:王韬 班级:生 76 组号:7-2 组 同组人:袁堂谧 实验日期:2009-11-26 一、 实验目的: 1
了解物理因素、化学因素及生物因素抑制或杀死微生物的作用及其试验方法
了解紫外诱变的原理和紫外诱变在育种方面的应用
练习单菌落划线分离微生物
二、 实验原理: 1
微生物对微生物的影响:温度通过影响酶活力、蛋白质和核酸的活性来影响细胞新陈代谢
微生物群体生长、繁殖最快的温度是微生物生存的最适温度
但不一定是积累某一代谢产物的最适温度
黏质赛氏杆菌能产生红色或紫红色色素,菌落表面颜色随着色素量的增加呈现出由橙黄到深红色逐渐加深的变化趋势
化学因素对微生物的影响:多种化学物质通过不同原理影响微生物的生长
例如重金属离子可以与菌体蛋白质结合而使之变形
有机溶剂可以使蛋白质和核酸变性或溶解细胞膜
生物因素对微生物的影响:许多细菌在生命过程中产生某些特殊的代谢产物如抗生素
这些物质可以影响其它微生物的生长
青霉素对革兰氏阳性菌的作用强于阴性菌
链霉素作用于原核生物
紫外线对微生物的影响: 1) 紫外线具有杀菌作用,主要因为它诱导形成胸腺嘧啶二聚体来破坏DNA 的结构,使其不能行使正常功能
另外,空气在紫外线照射下产生臭氧,也有一定杀菌作用
紫外线杀菌最强的波长是 226-256nm
可见光能激活生物体中的光复活酶,使形成的二聚体拆开复原,部分或全部消除紫外线的作用,所以杀菌或诱变后的微生物应避光
2) 紫外线对细菌生长的作用
我们可以利用个体经紫外线照射后的遗传特性会发生改变这种特性来进行灭菌或菌种选育工作
紫外线诱变最有效的波长仅仅是253-265nm,一般紫外线杀菌灯所发出的紫外线波长大约有80%为254nm
三、 实验材料: 菌源